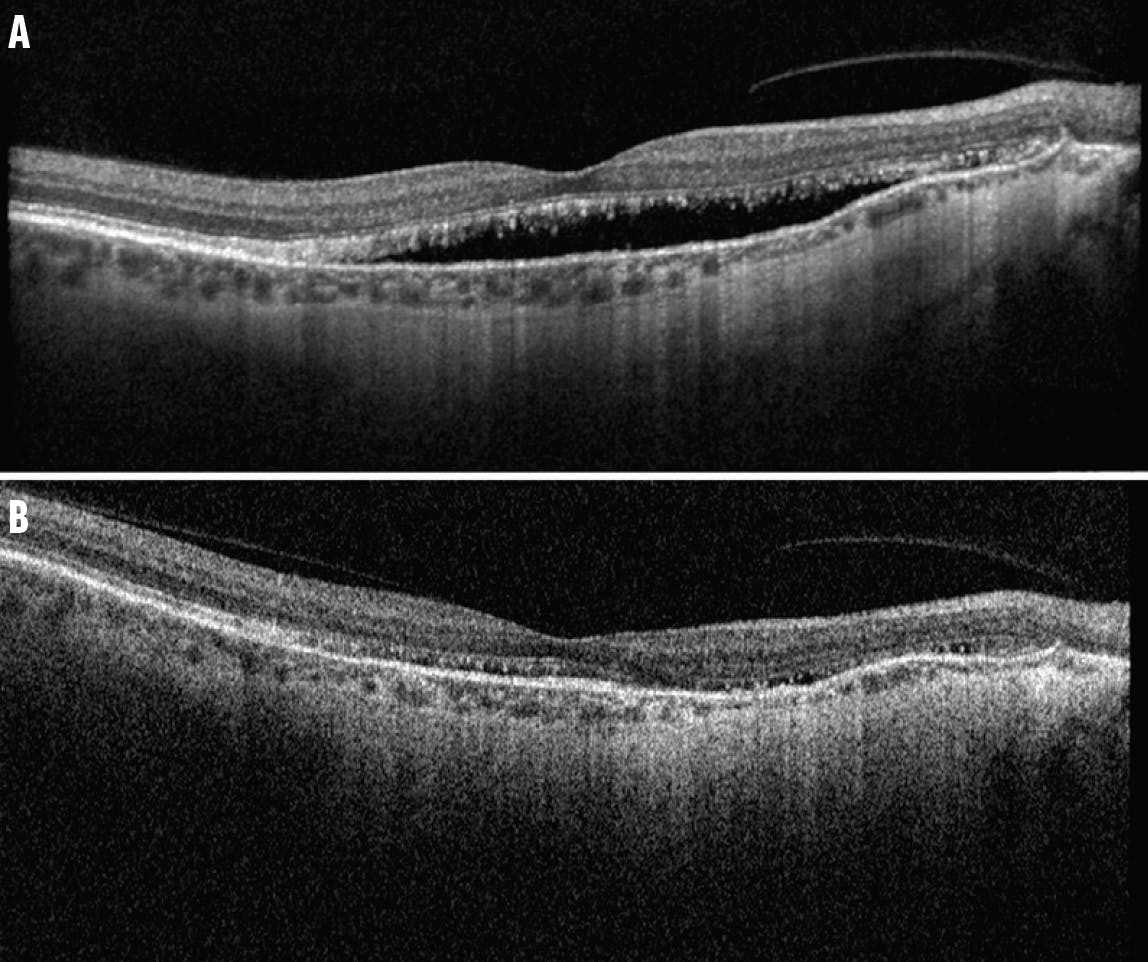

AT A GLANCE
- The authors found that the most commonly performed procedure in patients with an inherited retinal disease (IRD) is intravitreal injection of anti-VEGF medication for secondary choroidal neovascularization.
- The second most common procedure for patients with an IRD is intravitreal steroids for the suppression of cystoid macular edema and intraocular inflammation.
- Vitreoretinal surgery in patients with an IRD is typically indicated for the removal of vitreous hemorrhage or retinal detachment repair.
Currently, there is only one FDA-approved gene therapy to treat an inherited retinal disease (IRD), voretigene neparvovec-rzyl (Luxturna, Spark Therapeutics) for patients with biallelic RPE65 disease.1 Despite many gene and stem cell-based therapies under investigation, all other IRDs remain untreatable for the underlying cause of disease. However, it is important for retina specialists to remember that some patients may still require intervention. We recently reviewed our institutional experience of performing retinal procedures on more than 100 patients with IRDs and found that procedural and/or surgical interventions can be critical.2
SECONDARY CHOROIDAL NEOVASCULARIZATION
In our large cohort, the most commonly performed procedure in patients with an IRD was intravitreal injection of anti-VEGF medication for secondary choroidal neovascularization (CNV) in macular dystrophies such as pattern dystrophy, Best disease, and Stargardt disease.
Discerning the presence and activity of secondary CNV in patients with an IRD can be difficult. For instance, the presence of vitelliform deposits in Best disease make fluorescein angiography and OCT difficult to interpret. In an early characterization of Best disease by J. Donald M. Gass, CNV was considered a late-stage finding (ie, after the regression of the vitelliform lesion and the development of atrophy). However, using OCT angiography (OCTA), we have found that earlier stages of Best disease can also have CNV, including 50% of those with a typical vitelliform lesion (Gass stage 2).3
OCT characteristics such as focal choroidal excavations and nodular hyperreflective sub-retinal pigment epithelium pillars can hint at the presence of CNV.4
One of the most counter-intuitive yet characteristic signs of CNV activity in Best disease is an acute drop in visual acuity accompanied by diminution or resolution of subretinal material/fluid. This differs from most other macular diseases, in which the accumulation of subretinal material/fluid worsens vision. To explain this phenomenon, we proposed that when exudative fluid related to CNV enters the subretinal space, it changes the ionic composition of the subretinal fluid to a level that markedly differs from baseline. While vitelliform deposits tend to be well tolerated by photoreceptors, subretinal fluid from CNV is not, resulting in acute visual acuity decline. CNV activity reduces the amount of subretinal hyperreflective deposits, which return (along with visual acuity) after anti-VEGF injections cause CNV quiescence. Multiple injections may be required to see a complete rebound of subretinal material/fluid and vision, and the process can repeat itself later. Through careful monitoring and timely anti-VEGF injections, vitelliform lesions can sometimes be nurtured for years, avoiding the atrophic stage of Best disease and preserving vision (Figure 1).3

Figure 1. This patient with Best disease was treated with anti-VEGF injections for secondary CNV. Fundus photography showed a subfoveal vitelliform lesion (A, arrow). Baseline OCT confirmed the vitelliform lesion (B, arrow), and swept-source OCTA showed no apparent CNV. An acute decline in visual acuity coincided with partial collapse of the vitelliform material and a new hyperreflective sub-retinal pigment epithelium pillar (C, arrow), while OCTA showed new CNV. After anti-VEGF injection, the lesion regressed (D, arrow) with improved visual acuity and reconstitution of the vitelliform material as a paradoxically positive prognostic sign.
Similarly, in pseudoxanthoma elasticum (PXE), subretinal fluid may be present as a part of the disease process and is often not indicative of the presence of, or leakage from, CNV.5 Fluctuation and resolution of subretinal fluid can be observed in PXE without intervention (Figure 2). Like Best disease, a reduction in visual acuity, rather than the appearance of or changes in subretinal fluid, can hint at CNV activity and a change in the composition of the subretinal milieu in PXE. Similar phenomena can occur in patients with cuticular drusen.6 Thus, clinicians should not reflexively begin intravitreal anti-VEGF injections for any new subretinal fluid in patients with macular dystrophies, especially if there is no decline in visual acuity.
Figure 2. In this patient with PXE, the presence of subretinal fluid was not associated with active CNV on examination, OCT (A), or OCTA. Four years later, without any interventions, the fluid reduced spontaneously (B).
(Images courtesy of stonerounds.org)
INTRAOCULAR INFLAMMATION
In our cohort study, the second most common procedure for patients with an IRD was intravitreal steroids for the suppression of cystoid macular edema (CME) and intraocular inflammation.2 We used this modality primarily in autosomal-dominant neovascular inflammatory vitreoretinopathy, a very rare condition featuring retinal degeneration with progressive and relentless intraocular inflammation, CME, neovascularization of the retina and iris, vitreous hemorrhage, fibrosis, and tractional retinal detachments.7 Injectable steroid implants can provide longer-term control of uveitis, neovascularization, and CME. However, retinal fibrosis tends to continue and eventually requires vitreoretinal surgery.8 We do not advocate intravitreal steroids for CME or low-grade intraocular inflammation in more typical forms of IRD.
HEMORRHAGE AND DETACHMENTS
Vitreoretinal surgery in patients with an IRD is typically indicated for the removal of vitreous hemorrhage or retinal detachment repair (9.5% of patients with an IRD requiring a procedure in our cohort).2 Inherited vitreoretinopathies—including Stickler syndrome, Knobloch syndrome, and familial exudative vitreoretinopathy—often feature rhegmatogenous and/or tractional retinal detachments because of collagen composition defects or anomalous vascular proliferation (Figure 3). In X-linked retinoschisis, non-clearing vitreous hemorrhage or schisis detachments can occur. Cataract surgery complications such as dropped nuclei or dislocated IOLs are common in retinitis pigmentosa (RP) because of zonular instability. Epiretinal membranes in patients with an IRD are common but are rarely visually significant and can usually be observed.

Figure 3. Widefield fundus photography of the left eye of a young girl who presented with a VA of hand motion revealed a retinal detachment and a 7-clock-hour giant retinal tear, resulting in a folded retina nasally (A). After surgical repair with vitrectomy, scleral buckle, and silicone oil followed by secondary cataract surgery with oil removal, she regained a VA of 20/50 (B). Molecular investigation revealed a pathologic variant in COL2A1 consistent with Stickler syndrome.
CATARACTS
As retina specialists, we primarily focus on posterior segment procedures; however, deciding whether cataract surgery is indicated is a common clinical challenge, especially for patients with RP. In general, the preoperative integrity of the ellipsoid zone is indicative of better long-term visual outcomes from cataract surgery.9 Nguyen et al retrospectively looked at 296 patients with RP who underwent cataract extraction and found that 39% of patients had a visual improvement of at least 15 ETDRS letters.10 Interestingly, 73% of patients reported subjective improvement, which did not correspond to improved BCVA. This could be due, in part, to a placebo effect of surgery or unmeasured aspects of visual function (eg, color vision and contrast), which may not have been reported. The authors found a higher rate of zonular instability, posterior capsular opacification, and CME in these patients postoperatively.10 Careful postoperative monitoring and, if necessary, treatment of these complications is important.
TREAT WHAT YOU CAN
Although definitive treatments for the underlying genetic causes for most IRDs remain under investigation, secondary pathologies commonly require procedural and surgical interventions. Most commonly, injections of anti-VEGF agents for active CNV can improve vision in macular dystrophies, but clinicians must be aware of the counter-intuitive imaging findings often seen with Best disease and PXE. Close follow-up and timely treatment may enable clinicians to preserve vision in many of these patients until more definitive gene and stem cell-based therapies are widely available, at which point many more patients with IRDs will likely merit surgical intervention.
1. Russell S, Bennett J, Wellman JA, et al. Efficacy and safety of voretigene neparvovec (AAV2-hRPE65v2) in patients with RPE65-mediated inherited retinal dystrophy: a randomised, controlled, open-label, phase 3 trial. Lancet. 2017;390(10097):849-860. Erratum in: Lancet. 2017;390(10097):848.
2. Fenner BJ, Jamshidi F, Bhuyan R, et al. Vitreoretinal procedures in patients with inherited retinal disease. Ophthalmol Retina. 2024;8(3):307-309.
3. Han IC, Coussa RG, Mansoor M, et al. Choroidal neovascularization is common in best vitelliform macular dystrophy and plays a role in vitelliform lesion evolution. Ophthalmol Retina. 2023;7(5):441-449.
4. Coussa RG, Fortenbach CR, Critser DB, et al. Correlation of features on OCT with visual acuity and Gass lesion type in Best vitelliform macular dystrophy. BMJ Open Ophthalmol. 2021;6(1):e000860.
5. Zweifel SA, Imamura Y, Freund KB, Spaide RF. Multimodal fundus imaging of pseudoxanthoma elasticum. Retina. 2011;31(3):482-491.
6. Gass JD, Jallow S, Davis B. Adult vitelliform macular detachment occurring in patients with basal laminar drusen. Am J Ophthalmol. 1985;99(4):445-459.
7. Boyce TM, Whitmore SS, Varzavand K, et al. Long-Term outcomes and risk factors for severe vision loss in autosomal dominant neovascular inflammatory vitreoretinopathy (ADNIV). Am J Ophthalmol. 2022;233:144-152.
8. Tlucek PS, Folk JC, Orien JA, Stone EM, Mahajan VB. Inhibition of neovascularization but not fibrosis with the fluocinolone acetonide implant in autosomal dominant neovascular inflammatory vitreoretinopathy. Arch Ophthalmol. 2012;130(11):1395-1401.
9. Nakamura S, Fujiwara K, Yoshida N, et al. Long-term outcomes of cataract surgery in patients with retinitis pigmentosa. Ophthalmol Retina. 2022;6(4):268-272.
10. Nguyen XT, Thiadens AAHJ, Fiocco M, et al. Outcome of cataract surgery in patients with retinitis pigmentosa. Am J Ophthalmol. 2023;246:1-9.

























